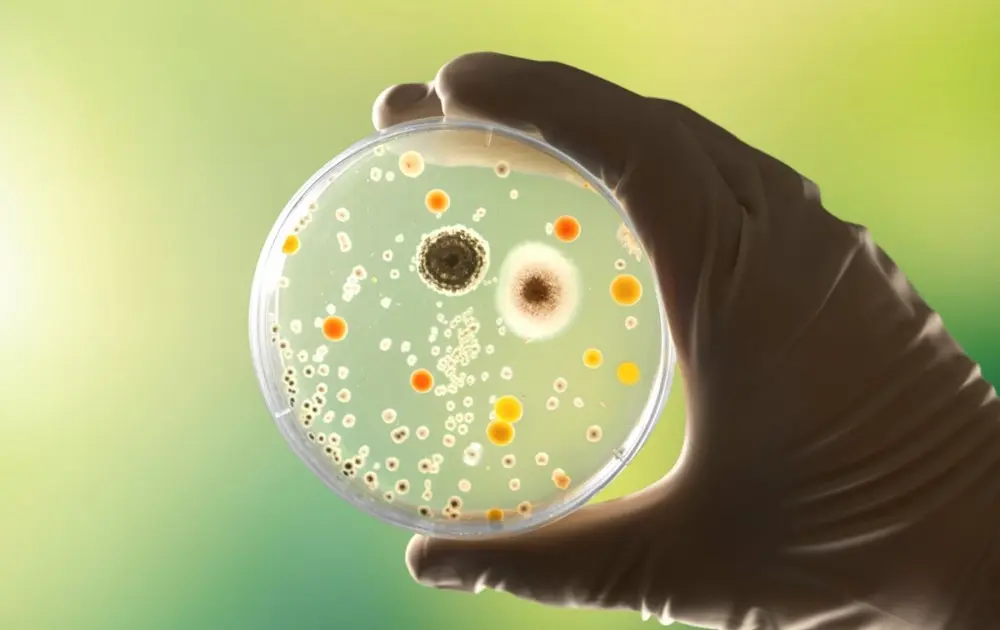

Международная группа ученых под руководством Наньянского технологического университета в Сингапуре (NTU Singapore) открыла новый способ, который может ускорить заживление хронических ран, инфицированных бактериями, устойчивыми к антибиотикам.
Во всем мире хронические раны представляют собой серьезную проблему для здоровья: по оценкам, ежегодно около 18,6 миллионов человек заболевают диабетическими язвами стопы. До одной трети людей с диабетом подвержены риску развития язвы стопы в течение жизни.
Эти раны являются одной из основных причин ампутаций нижних конечностей и часто осложняются стойкими инфекциями, препятствующими заживлению.
В Сингапуре хронические раны, такие как диабетические язвы стопы, пролежни и венозные язвы ног, становятся все более распространенными, ежегодно регистрируется более 16 000 случаев, особенно среди пожилых людей и людей с диабетом.
В исследовании, проведенном совместно с коллегами из Женевского университета в Швейцарии и опубликованном в журнале Science Advances , показано, как распространенная бактерия Enterococcus faecalis (E. faecalis) активно препятствует заживлению ран. Команда также продемонстрировала, как нейтрализация этого биологического процесса может позволить клеткам кожи восстановиться и закрыть раны.
E. faecalis — это условно-патогенный микроорганизм, часто встречающийся при хронических инфекциях, таких как диабетические язвы стопы. Эти раны трудно поддаются лечению и часто не заживают, что увеличивает риск осложнений и ампутации.
Устойчивость к антибиотикам также вызывает все большую обеспокоенность в отношении E. faecalis , причем некоторые штаммы устойчивы к нескольким широко используемым антибиотикам, что затрудняет лечение определенных инфекций.
Хотя известно, что подобные инфекции замедляют заживление, биологический механизм, лежащий в основе этого нарушения, до сих пор остается неясным для врачей и ученых.
Исследование проводится под совместным руководством доцента NTU Гийома Тибо из Школы биологических наук и профессора Кимберли Клайн из Женевского университета, которая является приглашенным профессором в SCELSE – Сингапурском центре экологических наук о жизни и инженерии при NTU.
Исследователи обнаружили, что в отличие от других бактерий, которые вырабатывают токсины при инфицировании ран, E. faecalis производит метаболический продукт, называемый активными формами кислорода (АФК), который нарушает процесс заживления клеток кожи человека.
Механизм, нарушающий заживление ран
Первый автор статьи, научный сотрудник NTU доктор Аарон Тан, обнаружил, что E. faecalis использует метаболический процесс, известный как внеклеточный электронный транспорт (ВЭТ), который непрерывно производит перекись водорода — высокореактивный вид кислорода, способный повреждать живые ткани.
Присутствуя в инфицированных ранах, эта бактерия вырабатывает перекись водорода, которая повреждает клетки кожи человека посредством окислительного стресса.
Лабораторные эксперименты показали, что окислительный стресс запускает в клетках кожи, называемых кератиноцитами, механизм клеточной защиты, известный как «реакция на неправильное сворачивание белков», который отвечает за восстановление кожи.
Эта реакция на неправильное сворачивание белков обычно используется клетками для борьбы с повреждениями путем замедления производства белков и других жизненно важных процессов, чтобы они могли восстановиться.
После активации стрессовая реакция фактически парализует клетки, препятствуя их движению для закрытия раны — процессу, известному как миграция.
Когда исследователи использовали генетически модифицированный штамм E. faecalis , у которого отсутствовал путь EET, бактерии вырабатывали значительно меньше перекиси водорода и не могли блокировать заживление ран.
Это подтвердило, что метаболический путь играет центральную роль в способности бактерии нарушать процессы восстановления кожи. Затем команда проверила, может ли нейтрализация перекиси водорода обратить вспять повреждения.
Возможное решение, позволяющее обойти устойчивость к антибиотикам
Обработав пораженные клетки кожи каталазой — природным антиоксидантным ферментом, расщепляющим перекись водорода, — исследователи снизили клеточный стресс и тем самым восстановили способность клеток к миграции и заживлению.
Это предлагает еще одно решение для борьбы с устойчивыми к антибиотикам штаммами E. faecalis , вместо попыток уничтожить или подавить их распространение с помощью антибиотиков.
«Наши результаты показывают, что оружие заключается в самом метаболизме бактерий, что стало неожиданностью и ранее было неизвестно ученым», — сказал доцент Тибо, который также является заместителем декана по международным связям в Колледже естественных наук.
«Вместо того чтобы сосредотачиваться на уничтожении бактерий антибиотиками, что становится все сложнее и приводит к развитию антибиотикорезистентности в будущем, мы теперь можем нейтрализовать их, блокируя вырабатываемые ими вредные продукты и восстанавливая заживление ран. Вместо того чтобы воздействовать на источник, мы нейтрализуем истинную причину хронических ран – активные формы кислорода».
Данное исследование устанавливает прямую связь между метаболизмом бактерий и дисфункцией клеток организма-хозяина, предлагая новую терапевтическую стратегию для лечения хронических ран.
Исследователи предполагают, что в будущем перевязочные материалы, содержащие антиоксиданты, такие как каталаза, могут стать эффективным методом лечения.
Поскольку антиоксиданты, такие как каталаза, уже широко используются и хорошо изучены, исследователи считают, что эта стратегия может сократить путь от лабораторных исследований до клинического применения по сравнению с разработкой нового лекарственного препарата.
Поскольку в исследовании для демонстрации механизма использовались клетки кожи человека, полученные результаты имеют отношение к физиологии человека и могут проложить путь к новым методам лечения пациентов с незаживающими ранами.
Команда планирует перейти к клиническим испытаниям на людях после определения наиболее эффективного способа доставки антиоксидантов в ходе текущих исследований на животных моделях.
Источник: Наньянский технологический университет